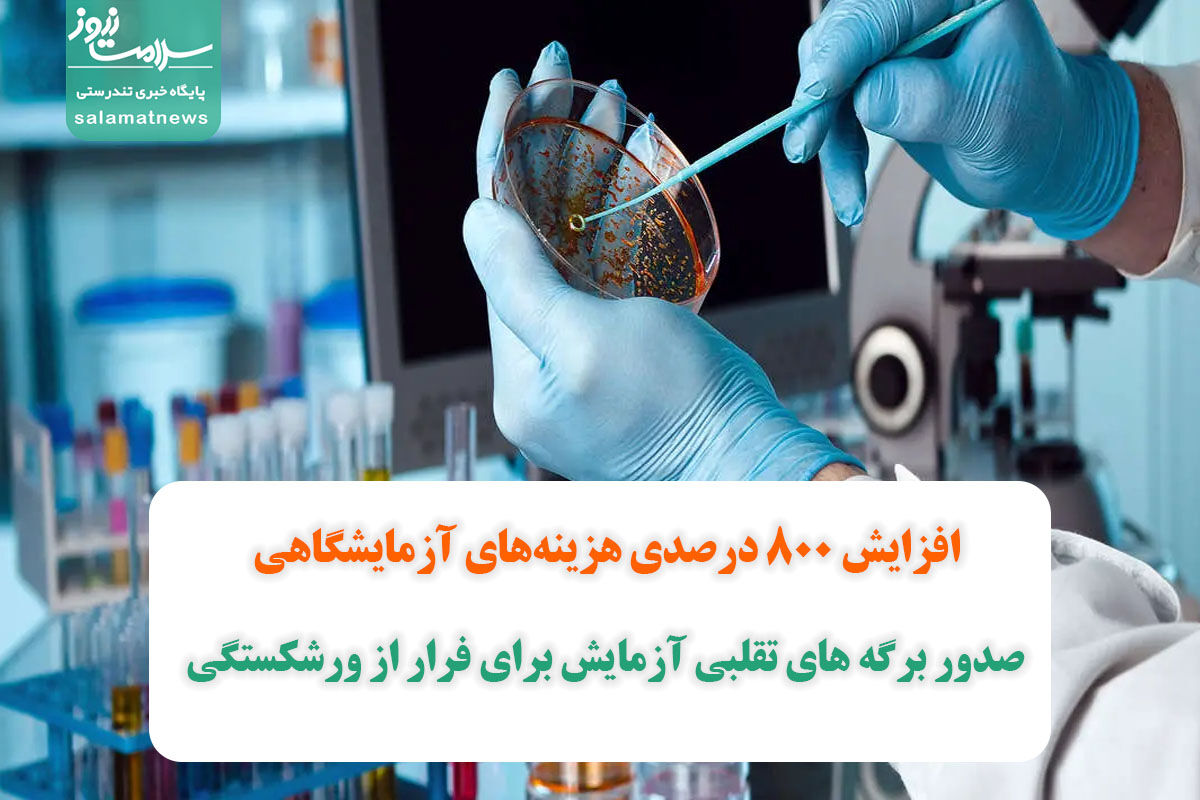

به گزارش سلامت نیوز به نقل از تجارت نیوز، روز گذشته رئیس انجمن متخصصان علوم آزمایشگاهی با اشاره به افزایش قیمت تجهیزات آزمایشگاهی اعلام کرد به دلیل بالا رفتن قیمت دلار امکان تهیه تجهیزات و قطعات آزمایشگاهی مشکلی است که آزمایشگاهها با آن مواجه هستند. در این شرایط حتی فروشندگان هم با دریافت روزانه قیمت دلار به آزمایشگاهها اعلام قیمت میکنند و ادامه چنین روندی باعث میشود هزینههای آزمایشگاهی حتی 800 برابر نیز افزایش پیدا کند.
چنین اتفاقی در شرایطی رخ میدهد که همین الان هم حوزه بهداشت و درمان با مشکلات زیادی مواجه است. هرچند وزیر بهداشت و معاونان او نسبت به بروز این مشکلات، همیشه سیاست تکذیب را در پیش گرفتهاند اما واقعیتی که در جامعه جریان دارد حاکی از نارضایتی مردم از روند درمان در بیمارستانهای دولتی، گرانی و کمبود دارو و مشکلات دیگری است که حتی باعث میشود بسیاری از افراد ناچار از چرخه درمان خارج شوند.
مساله مهم دیگر این است که حوزه بهداشت و درمان با سلامت و جان انسانها سروکار دارد و هرگونه کمی و کاستی در این حوزه میتواند به قیمت جان و سلامت بیماران تمام شود؛ مسالهای که بارها کارشناسان حوزه سلامت به آن اشاره کردهاند اما هر بار متولیان این حوزه با بیتفاوتی از کنار این مشکلات گذشته و تنها به تکذیب اخبار بسنده کردهاند.
مشکلات موجود در حوزه بهداشت و درمان زمانی بیشتر شد که دولت تصمیم گرفت ارز نیمایی دارو را حذف کند و جای آن تعهداتی به مجلس داد که گویا در عمل به آنها چندان هم کوشا نبوده و به همین خاطر است که از آن زمان تاکنون نهتنها مشکلات موجود در حوزه بهداشت و درمان کمتر نشده که هر روز مشکلاتی تازه به این بخش افزوده میشود.
آزمایشگاهها به سمت راههای غیرقانونی روی میآورند
ایرج خسرونیا، رئیس انجمن متخصصان داخلی، دراینباره به تجارتنیوز میگوید: «متاسفانه افزایش قیمت دلار در تمامی ابعاد زندگی مردم تاثیر منفی گذاشته است. در واقع این افزایش باعث شده مشکلات حوزه بهداشت و درمان افزایش یابد و فشار این مشکلات بر جامعه پزشکی و مردم بیش از همه وارد میشود.»
او میافزاید: «هر موسسه و بنگاهی که در زمینههای خدماتی کار میکند قطعاً باید بتواند از پس تامین هزینههای خود بربیاید؛ اگر شرایط برای این تامین فراهم نباشد، قطعاً مجبور میشوند بین ورشکستگی و روی آوردن به راههای غیرقانونی کسب درآمد یکی را انتخاب کنند. در هر دو صورت این مردم هستند که ضرر میکنند و از دریافت خدمات باکیفیت محروم میشوند.»
خسرونیا میگوید: «متاسفانه دولت به هیچ کدام از تعهداتی که زمان حذف ارز نیمایی دارو به مجلس داده بود عمل نکرده و همین مساله هم باعث شده وضعیت بهداشت و درمان چنین شرایط بد و بحرانیای پیدا کند.»
او درباره راههای غیرقانونی کسب درآمد توضیح میدهد: «وقتی آزمایشگاه توان تامین هزینههای خود را نداشته باشد و امکان تامین تجهیزات به علت گرانی از او سلب شود، یا مجبور است کسبوکار خود را تعطیل کند یا به ارائه برگههای جواب آزمایش به بیماران در حالی که اصلاً آزمایشی انجام نشده یا استفاده از وسایل و کیتهای قدیمی که قطعاً نتیجه درستی ندارند، روی بیاورد. در این شرایط بیش از همه این بیماران هستند که در معرض خطر قرار میگیرند.»
خسرونیا در بخش دیگری از صحبتهای خود میگوید: «متاسفانه به دلیل همین بدعهدیهای دولت در زمینه تعهداتی که به حوزه بهداشت و درمان داده و افزایش قیمت خدمات و داروها و... بسیاری از بیماران مجبور به ترک چرخه درمان میشوند. فردی که برای تامین معیشت خود دچار مشکل است، قطعاً برای پرداخت هزینههای درمانی مشکلات بیشتری دارد.»
او در پایان میگوید: «این بیتوجهیها در نهایت به مهاجرت بیشتر پزشکان و متخصصان و کادر درمان میانجامد؛ از سوی دیگر کیفیت خدمات در بیمارستانهای دولتی را بهشدت کاهش میدهد و در نهایت باعث ورشکستگی مراکز درمانی و آزمایشگاهها و تعطیلی آنها میشود.»
سیاست غلط دولت در حوزه اقتصاد، تمام بخشها را به دردسر انداخته
سینا مهدوی، کارشناس اقتصادی، نیز دراینباره میگوید: «متاسفانه سیاستهای اشتباه اقتصادی که دولت طی این سالها در پیش گرفته، منجر به کاهش ارزش پول ملی و در نتیجه بروز مشکلات در تمامی بخشها از جمله حوزه بهداشت و درمان شده است.»
او اضافه میکند: «این ابراز نگرانی رئیس انجمن متخصصان علوم آزمایشگاهی کاملاً بجاست چراکه وقتی هزینه دریافت خدمات درمانی افزایش بیرویه پیدا کند، قطعاً هم به ضرر این مراکز خواهد بود و بیشتر از همه به ضرر بیماران تمام میشود. اولین اتفاقی که رخ میدهد کاهش کیفیت خدمات است. همانطور که وقتی تولیدکننده با افزایش هزینه تولید مواجه میشود، قطعاً دو راه بیشتر برایش باقی نمیماند؛ یا کیفیت کالا را کاهش یا قیمت آن را افزایش دهد. در زمینه خدمات درمانی هم همین اتفاق میافتد؛ با این تفاوت که هرگونه کم کردن کیفیت این خدمات میتواند به قیمت جان بیماران تمام شود.»
مهدوی در پایان میگوید: «مساله اینجاست که باور مسئولان و متولیان حوزه بهداشت و درمان در مورد مشکلات این حوزه با آن چیزی که در واقعیت جریان دارد کاملاً متفاوت است و تا زمانی که این تفاوت از میان برداشته نشود نمیتوان امید داشت که روند بهبود وضعیت از سرعت مناسبی برخوردار باشد.»

نظر شما